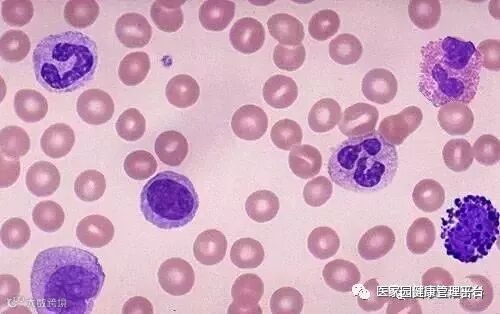

近几年,干细胞的研究进展迅速,在多方面取得了实质性进展,下面介绍几个干细胞治疗的新发现和有效案例。
1. 上海交大医学院发现清除白血病干细胞的潜在新靶点
白血病干细胞是与白血病发生、发展和复发有关的一群细胞,在白血病干细胞上发现新的治疗靶点对于彻底治愈白血病有至关重要的意义。
最近来自上海交通大学医学院的郑俊克和陈国强院士等人在白血病干细胞上发现了一个高表达的基因,并揭示了该基因参与白血病发生的重要机制。相关研究结果发表在国际学术期刊JCI上。
2.干细胞疗法治疗黄斑退化
2015年6月, 86岁的Douglas Waters出现了严重的老年性黄斑变性症状(AMD),导致难以看清东西。在手术之前,Douglas的视力很差,右眼几乎看不到任何东西。而手术之后,他的视力恢复地很快,能够阅读报纸以及干一些农活。将从干细胞诱导而来的,工程化的视网膜色素上皮细胞移植进入患者的眼睛中,从而帮助AMD患者重建光明。结果表明该方法具有安全性以及有效性。
黄斑变性是发达国家中造成50岁以上人群视力损伤的主要原因。该疾病的发生主要是由于血管病变导致血液难以进入视网膜的中心黄斑区域。在这项研究中,作者希望能够使用干细胞将患者眼部后侧受损的细胞置换,从而恢复患者的视力。该手术总共耗时大概1到2小时。除了Douglas之外,该试验中还有一名60岁的女性患者。在手术后的12个月内,她与Douglas两人的视力恢复水平都十分显著。此前他们都几乎无法阅读,而手术之后则能够在佩戴正常眼镜的情况下每分钟阅读60-80个字。
3.干细胞疗法能够修复更年期的过早出现以及生育问题
通过自体骨髓移植的手段能够使因卵巢功能早衰而生育力下降的女性重新恢复生育能力,而且避免过早地进入更年期。
在接受治疗的两名受体中,发现其血清雌激素水平在接受干细胞移植后的三个月后出现了明显升高,而且该效应能够持续一年之久。患者的更年期症状得到了缓解。干细胞移植六个月后其经期得到了重新恢复。
研究者从每名患者的髂嵴处提取了间叶干细胞并且通过微创腹腔镜的手段将细胞注入自身一侧卵巢中,同时保证另外一侧卵巢不受影响。之后,定期对患者的血常规、卵巢成像以及更年期症状进行调查。发现接受治疗的女性其雌激素水平有明显上升,而且开始出现经期反应。
干细胞的研究使人类能够再造生物组织器官,不仅有助于科学家研究生物组织器官的发育、进行药物筛查等,还可用于再生医疗,帮助更多疾病患者减轻痛苦。随着干细胞研究的发展,人类的疾病和生命会得到更好的帮助和延续。
医家园健康管理平台
医家园
精准 - 快速 - 全面